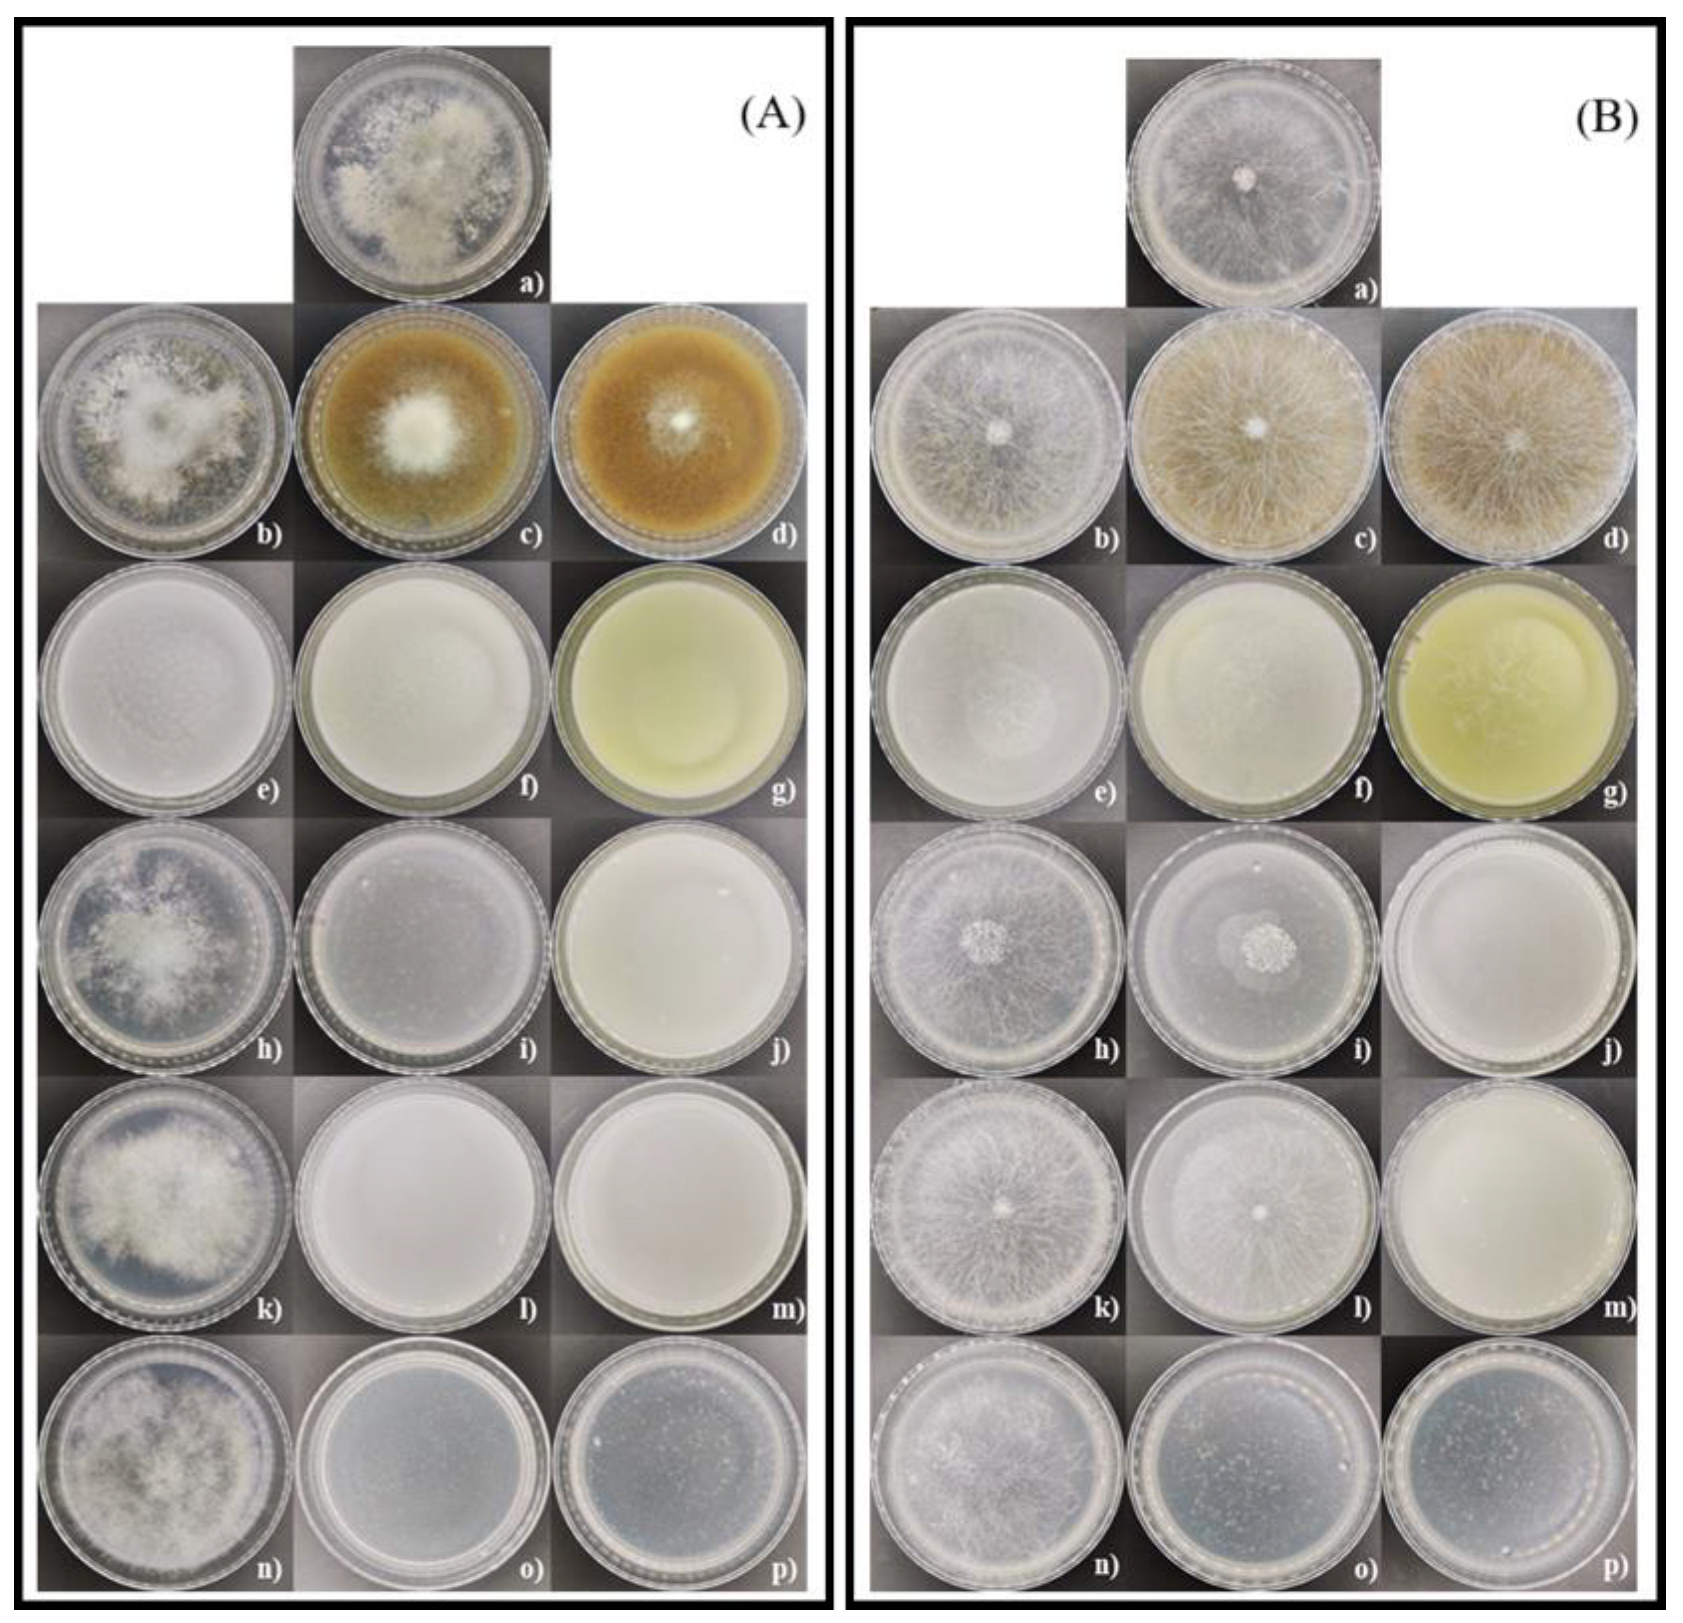
Resources 14 00048 g007

Coffee By-Products and Chitosan for Preventing Contamination for Botrytis sp. and Rhizopus sp. in Blueberry Commercialization
Abstract
:1. Introduction
2. Materials and Methods
2.1. Materials
2.2. Characterization of Coffee Oil by Gas Chromatography and Mass Spectrometry (GC-MS)
2.3. Characterization of CP by Liquid Chromatography and Mass Spectrometry (HPLC-MS)
2.4. Environmental Scanning Electron Microscopy (ESEM-EDS)
2.5. Nanoparticles and Nanostructured Coating Elaboration
2.6. Funtional Groups of CP, GCBO, and ChNp by FTIR
2.7. Incorporation of Coffee Waste and NC in a Polymeric Matrix
2.8. Fungal Genera
2.9. Mycelial Growth Inhibition
2.10. Spore Germination Inhibition
2.11. In Vivo Evaluation
2.12. In Vitro Assay for the PM
2.13. Statistical Analysis
3. Results
3.1. Characterization of Green Coffee Bean Oil by GC-MS
3.2. High-Performance Liquid Chromatography (HPLC) Analysis
3.3. Elemental Analysis of Coffee Parchment
3.4. Identification of Funtional Groups of CP, GCBO, and ChNp by FTIR
3.5. In Vitro Effect of Coffee Residues, Chitosan, and Chitosan Nanoparticles on Mycelial Growth and Spore Germination Inhibition of Botrytis sp. and Rhizopus sp.
3.6. In Vitro Assay of Coffee Residues and Incubation Times on Mycelial Growth and Spore Germination Inhibition of Botrytis sp. and Rhizopus sp.
3.7. In Vivo Effect
3.8. In Vitro Assay of Coffee Residues Incorporated into the PM
4. Discussion
5. Conclusions
Author Contributions
Funding
Data Availability Statement
Acknowledgments
Conflicts of Interest
Abbreviations
| PLA | Polylactic acid |
| PBAT | Poly(butylene adipate-co-terephthalate) |
| CP | Coffee parchment |
| GCBO | Green coffee bean oil |
| Ch | Chitosan solution |
| ChNp | Chitosan nanoparticles |
| PM | Polymer matrix |
| PM+CW | Polymer matrix with coffee waste |
| TLA | Three letter acronym |
| NC | Nanostructured coating |
| PPCP | Polylactic acid/Poly(butylene adipate-co-terephthalate)+ Coffee parchment |
| PP+NC | Polylactic acid/Poly(butylene adipate-co-terephthalate)+ Nanostructured coating |
| PPCP+NC | Polylactic acid/Poly(butylene adipate-co-terephthalate)+ Coffee parchment+ Nanostructured coating |
| GC-MS | Gas chromatography and mass spectrometry |
| HPLC-MS | Liquid chromatography and mass spectrometry |
| ESEM-EDS | Environmental scanning electron microscopy |
| MI | Mycelial inhibition |
| Gr | Growth rate |
| DF | Diameter of the final growth |
| DI | Diameter of the initial growth |
| SGI | Spore germination inhibition |
| MGR | Mycelial growth rate |
| NG | No growth |
| NSF | No spore germination |
References
- Banerjee, S.; Nayik, G.A.; Kour, J.; Nazir, N. Blueberries. In Antioxidants in Fruits: Properties and Health Benefits; Nayik, G.A., Gull, A., Eds.; Springer: Singapore, 2020; pp. 593–614. [Google Scholar]
- Bell, S.R.; Montiel, L.G.; Estrada, R.R.; Martínez, P. Main diseases in postharvest blueberries, conventional and eco-friendly control methods: A review. LWT 2021, 149, 112046. [Google Scholar] [CrossRef]
- Scherm, H.; Savelle, A.T.; Brannen, P.M.; Krewer, G. Occurrence and prevalence of foliar diseases on blueberry in Georgia. Plant Health Prog. 2008, 9, 18. [Google Scholar] [CrossRef]
- Garfinkel, A.R. The history of Botrytis taxonomy, the rise of phylogenetics, and implications for species recognition. Phytopathology 2021, 111, 437–454. [Google Scholar] [CrossRef]
- Agrios, G.N. Plant Pathology, 5th ed.; Elsevier Academic Press: San Diego, CA, USA, 2012; p. 948. [Google Scholar]
- O’Brien, P.A. Biological control of plant diseases. Australas. Plant Pathol. 2017, 46, 293–304. [Google Scholar] [CrossRef]
- Gwinn, K.D. Bioactive Natural Products in Plant Disease Control. In Studies in Natural Products Chemistry; Elsevier B.V.: Amsterdam, The Netherlands, 2018; Volume 56, pp. 229–246. [Google Scholar]
- Klingel, T.; Kremer, J.I.; Gottstein, V.; Rajcic de Rezende, T.; Schwarz, S.; Lachenmeier, D.W. A Review of Coffee By-Products Including Leaf, Flower, Cherry, Husk, Silver Skin, and Spent Grounds as Novel Foods within the European Union. Foods 2020, 9, 665. [Google Scholar] [CrossRef]
- Dong, W.; Chen, Q.; Wei, C.; Hu, R.; Long, Y.; Zong, Y.; Chu, Z. Comparison of the effect of extraction methods on the quality of green coffee oil from Arabica coffee beans: Lipid yield, fatty acid composition, bioactive components, and antioxidant activity. Ultrason. Sonochemistry 2021, 74, 105578. [Google Scholar] [CrossRef]
- Mirón-Mérida, V.A.; Yáñez-Fernández, J.; Montañez-Barragán, B.; Barragán Huerta, B.E. Valorization of coffee parchment waste (Coffea arabica) as a source of caffeine and phenolic compounds in antifungal gellan gum films. LWT 2019, 101, 167–174. [Google Scholar] [CrossRef]
- Hashemi, B.; Shiri, F.; Švec, F.; Nováková, L. Green solvents and approaches recently applied for extraction of natural bioactive compounds. TrAC 2022, 157, 116732. [Google Scholar] [CrossRef]
- Gloria, M.B.A.; Almeida, A.A.P.; Engeseth, N. Antimicrobial activity of coffee. In Coffee: Consumption and Health Implicarions; Farah, A., Ed.; The Royal Society of Chemistry: London, UK, 2019; pp. 234–254. [Google Scholar]
- Chaves-Ulate, E.; Esquivel-Rodríguez, P. Ácidos clorogénicos presentes en el café: Capacidad antimicrobiana y antioxidante. Agron. Mesoam. 2019, 30, 299–311. [Google Scholar] [CrossRef]
- Verlee, A.; Mincke, S.; Stevens, C.V. Recent developments in antibacterial and antifungal chitosan and its derivatives. Carbohydr. Polym. 2017, 164, 268–283. [Google Scholar] [CrossRef]
- Ding, L.; Huang, Y.; Cai, X.; Wang, S. Impact of pH, ionic strength and chitosan charge density on chitosan/casein complexation and phase behavior. Carbohydr. Polym. 2019, 208, 133–141. [Google Scholar] [CrossRef]
- Saberi Riseh, R.; Vatankhah, M.; Hassanisaadi, M.; Shafiei-Hematabad, Z.; Kennedy, J.F. Advancements in coating technologies: Unveiling the potential of chitosan for the preservation of fruits and vegetables. Int. J. Biol. Marcromolecules 2024, 254, 127677. [Google Scholar] [CrossRef] [PubMed]
- Sotelo-Boyás, M.E.; Correa-Pacheco, Z.N.; Bautista-Baños, S.; Corona-Rangel, M.L. Physicochemical characterization of chitosan nanoparticles and nanocapsules incorporated with lime essential oil and their antibacterial activity against food-borne pathogens. LWT 2017, 77, 15–20. [Google Scholar] [CrossRef]
- Moore, C.J. Synthetic polymers in the marine environment: A rapidly increasing, long-term theat. Environ. Res. 2008, 108, 131–139. [Google Scholar] [CrossRef] [PubMed]
- Rives-Castillo, S.C.H.; Bautista-Baños, S.; Correa-Pacheco, Z.N.; Ventura-Aguilar, R.I. Situación actual de los envases utilizados para la conservación postcosecha de productos hortofrutícolas. Rev. Iberoam. Tecnol. Postcosecha 2020, 21, 17–34. [Google Scholar]
- Pang, X.; Zhuang, X.; Tang, Z.; Chen, X. Polylactic acid (PLA): Research, development and industrialization. Biotechnol. J. 2010, 5, 1125–1136. [Google Scholar] [CrossRef]
- Ferreira, F.V.; Cividanes, L.S.; Gouveia, R.F.; Lona, L.M. An overview on properties and applications of poly (butylene adipate-co-terephthalate)—PBAT based composites. Polym. Eng. Sci. 2017, 59 (Suppl. S2), E7–E15. [Google Scholar] [CrossRef]
- Castellón-Castro, C.A.; Tejeda-López, L.N.; Tejeda-Benítez, L.P. Evaluación de la degradación ambiental de bolsas plásticas biodegradables. Inf. Técnico 2016, 80, 24–31. [Google Scholar] [CrossRef]
- Soquetta, M.B.; Terra, L.D.M.; Bastos, C.P. Green technologies for the extraction of bioactive compounds in fruits and vegetables. CyTA-J. Food 2018, 16, 400–412. [Google Scholar] [CrossRef]
- Sultana, T.; Dey, S.C.; Molla, M.A.I.; Hossain, M.R.; Rahman, M.M.; Quddus, M.S.; Moniruzzaman, M.; Rahman, M.M. Facile synthesis of TiO2/Chitosan nanohybrid for adsorption-assisted rapid photodegradation of an azo dye in water. React. Kinet. Mech. Catal. 2021, 133, 1121–1139. [Google Scholar] [CrossRef]
- Andrea, M.J.; Mariana, P.G.; Mónica, H.L.; Nacary, C.P.Z.; Silvia, B.B.; Laura, B.N. Nanostructured Chitosan Coating with a Coffee Residue Extract for the Preservation of Tomato and Controlling Pre- and Postharvest Disease Caused by Rhizopus stolonifer. Processes 2025, 13, 220. [Google Scholar] [CrossRef]
- González-Quijano, G.; Arrieta, B.D.; Dorantes, A.L.; Aparicio, O.G.; Guerrero, L.I. Effect of extraction method in the content of phytoestrogens and main phenolics in mesquite pod extracts (Prosopis sp.). Rev. Mex. De Ing. Química 2019, 18, 303–312. [Google Scholar] [CrossRef]
- Istúriz-Zapata, M.A.; Correa-Pacheco, Z.N.; Bautista-Baños, S.; Acosta-Rodríguez, J.L.; Hernández-López, M.; Barrera-Necha, L.L. Efficacy of extracts of mango residues loaded in chitosan nanoparticles and their nanocoatings on in vitro and in vivo postharvest fungal. J. Phytopathol. 2022, 170, 661–674. [Google Scholar] [CrossRef]
- Istúriz-Zapata, M.A.; Hernández-López, M.; Correa-Pacheco, Z.N.; Barrera-Necha, L.L. Quality of cold-stored cucumber as affected by nanostructured coatings of chitosan with cinnamon essential oil and cinnamaldehyde. LWT 2020, 123, 109089. [Google Scholar] [CrossRef]
- Correa-Pacheco, Z.N.; Black-Solís, J.D.; Ortega-Gudiño, P.; Sabino-Gutiérrez, M.A.; Benítez-Jiménez, J.J.; Barajas-Cervantes, A.; Bautista-Baños, S.; Hurtado-Colmenares, L.B. Preparation and characterization of bio-based PLA/PBAT and cinnamon essential oil polymer fibers and life-cycle assessment from hydrolytic degradation. Polymers 2019, 12, 38. [Google Scholar] [CrossRef]
- Hernández-López, M.; Correa-Pacheco, Z.N.; Bautista-Baños, S.; Zavaleta-Avejar, L.; Benítez-Jiménez, J.J.; Sabino-Gutiérrez, M.A.; Ortega-Gudiño, P. Bio-based composite fibers from pine essential oil and PLA/PBAT polymer blend. Morphological, physicochemical, thermal and mechanical characterization. Mater. Chem. Phys. 2019, 234, 345–353. [Google Scholar] [CrossRef]
- Velázquez Silva, A.; Robles Yerena, L.; Barrera Necha, L.L. Chemical profile and antifungal activity of plant extracts on Colletotrichum spp. isolated from fruits of Pimenta dioica (L.) Merr. Pestic. Biochem. Physiol. 2021, 179, 104949. [Google Scholar] [CrossRef]
- Correa-Pacheco, Z.N.; Ventura-Aguilar, R.I.; Zavaleta-Avejar, L.; Barrera-Necha, L.L.; Hernández-López, M.; Bautista-Baños, S. Anthracnose Disease Control and Postharvest Quality of Hass Avocado Stored in Biobased PLA/PBAT/Pine Essential Oil/Chitosan Active Packaging Nets. Plants 2022, 11, 2278. [Google Scholar] [CrossRef]
- Gebeyehu, B.T.; Bikila, S.L. Determination of caffeine content and antioxidant activity of coffee. Am. J. Appl. Chem. 2015, 3, 69–76. [Google Scholar] [CrossRef]
- Reis, R.S.; Tienne, L.G.; Souza, D.H.S.; Maria de Fátima, V.M.; Monteiro, S.N. Characterization of coffee parchment and innovative steam explosion treatment to obtain microfibrillated cellulose as potential composite reinforcement. J. Mater. Res. Technol. 2020, 9, 9412–9421. [Google Scholar] [CrossRef]
- Aung Moon, S.; Wongsakul, S.; Kitazawa, H.; Kittiwachana, S.; Saengrayap, R. Application of ATR-FTIR for Green Arabica Bean Shelf-Life Determination in Accelerated Storage. Foods 2024, 13, 2331. [Google Scholar] [CrossRef] [PubMed]
- Sathiyabama, M.; Boomija, R.V.; Muthukumar, S.; Gandhi, M.; Salma, S.; Prinsha, T.K.; Rengasamy, B. Green synthesis of chitosan nanoparticles using tea extract and its antimicrobial activity against economically important phytopathogens of rice. Sci. Rep. 2024, 14, 7381. [Google Scholar] [CrossRef] [PubMed]
- AlEraky, D.M.; Abuohashinsh, H.M.; Gad, M.M.; Alshuyukh, M.H.; Bugshan, A.S.; Almulhim, K.S.; Mahmoud, M.M. The antifungal and antibiofilm activities of caffeine against Candida albicans on polymethyl methacrylate denture base material. Biomedicines 2022, 10, 2078. [Google Scholar] [CrossRef]
- Nonthakaew, A.; Matan, N.; Aewsiri, T.; Matan, N. Caffeine in foods and its antimicrobial activity. Int. Food Res. J. 2015, 22, 9–14. [Google Scholar]
- Oliveira, A.L.D.; Cruz, P.M.; Eberlin, M.N.; Cabral, F.A. Brazilian roasted coffee oil obtained by mechanical expelling: Compositional analysis by GC-MS. Food Sci. Technol. 2005, 25, 677–682. [Google Scholar] [CrossRef]
- Benyelles, M.; Merzouk, H.; Merzouk, A.Z.; Imessaoudene, A.; Medjdoub, A.; Mebarki, A. Valorization of Encapsulated Coffee Parchment Extracts as Metabolic Control for High Fructose Diet-Induced Obesity, Using Wistar Rat as Animal Model. Waste Biomass Valorization 2024, 15, 265–281. [Google Scholar] [CrossRef]
- Machado, M.; Espírito Santo, L.; Machado, S.; Lobo, J.C.; Costa, A.S.; Oliveira, M.B.P.; Ferreira, H.; Alves, R.C. Bioactive potential and chemical composition of coffee by-products: From pulp to silverskin. Foods 2023, 12, 2354. [Google Scholar] [CrossRef]
- Periferakis, A.; Periferakis, K.; Badarau, I.A.; Petran, E.M.; Popa, D.C.; Caruntu, A.; Costache, R.S.; Scheau, C.; Caruntu, C.; Costache, D.O. Kaempferol: Antimicrobial properties, sources, clinical, and traditional applications. Int. J. Mol. Sci. 2022, 23, 15054. [Google Scholar] [CrossRef]
- Ilk, S.; Saglam, N.; Özgen, M. Kaempferol loaded lecithin/chitosan nanoparticles: Preparation, characterization, and their potential applications as a sustainable antifungal agent. Artif. Cells Nanomed. Biotechnol. 2016, 45, 907–916. [Google Scholar] [CrossRef]
- Du, J.; Fu, J.; Chen, T. Investigation of the Antibacterial Properties and Mode of Action of Compounds from Urtica dioica L. Cureus 2024, 16, e52083. [Google Scholar] [CrossRef]
- Betts, J.; Wareham, D.; Haswell, S.; Kelly, S. Antifungal synergy of theaflavin and epicatechin combinations against Candida albicans. J. Microbiol. Biotechnol. 2013, 23, 1322–1326. [Google Scholar] [CrossRef] [PubMed]
- Banerjee, M.; Parai, D.; Chattopadhyay, S.; Mukherjee, S.K. Andrographolide: Antibacterial activity against common bacteria of human health concern and possible mechanism of action. Folia Microbiol. 2017, 62, 237–244. [Google Scholar] [CrossRef] [PubMed]
- Mussard, E.; Cesaro, A.; Lespessailles, E.; Legrain, B.; Berteina-Raboin, S.; Toumi, H. Andrographolide, a natural antioxidant: An update. Antioxidants 2019, 8, 571. [Google Scholar] [CrossRef]
- Mollica, A.; Scioli, G.; Della Valle, A.; Cichelli, A.; Novellino, E.; Bauer, M.; Kamysz, W.; Llorent-Martínez, E.L.; Fernández-de Córdova, M.L.; Castillo-López, R.; et al. Phenolic analysis and in vitro biological activity of red wine, pomace and grape seeds oil derived from Vitis vinifera L. cv. Montepulciano d’Abruzzo. Antioxidants 2021, 10, 1704. [Google Scholar] [CrossRef]
- Salem, M.Z.; Mohamed, A.A.; Ali, H.M.; Al Farraj, D.A. Characterization of phytoconstituents from alcoholic extracts of four woody species and their potential uses for management of six Fusarium oxysporum isolates identified from some plant hosts. Plants 2021, 10, 1325. [Google Scholar] [CrossRef]
- Coura, M.R.; Demuner, A.J.; Demuner, I.F.; Blank, D.E.; Magalhães Firmino, M.J.; Borges Gomes, F.J.; Macedo Ladeira Carvalho, A.M.; Moreira Costa, M.; Henrique dos Santos, M. Technical kraft lignin from coffee parchment. Nord. Pulp Pap. Res. J. 2023, 38, 229–241. [Google Scholar] [CrossRef]
- Tomizawa, M.; Kurosu, S.; Konayashi, M.; Kawase, Y. Zero-valent iron treatment of dark brown colored coffee effluent: Contributions of a core-shell structure to pollutant removals. J. Environ. Manag. 2016, 183, 478–487. [Google Scholar] [CrossRef]
- Ke, C.-L.; Deng, F.-S.; Chuang, C.-Y.; Lin, C.-H. Antimicrobial Actions and Applications of Chitosan. Polymers 2021, 13, 904. [Google Scholar] [CrossRef]
- Calheiros, D.; Dias, M.I.; Calhelha, R.C.; Barros, L.; Ferreira, I.C.F.R.; Fernandes, C.; Gonçalves, T. Antifungal Activity of Spent Coffee Ground Extracts. Microorganisms 2023, 11, 242. [Google Scholar] [CrossRef]
- Soylu, E.M.; Kurt, Ş.; Soylu, S. In vitro and in vivo antifungal activities of the essential oils of various plants against tomato grey mould disease agent Botrytis cinerea. Int. J. Food Microbiol. 2010, 143, 183–189. [Google Scholar] [CrossRef]
- Poznanski, P.; Hameed, A.; Orczyk, W. Chitosan and chitosan nanoparticles: Parameters enhancing antifungal activity. Molecules 2023, 28, 2996. [Google Scholar] [CrossRef] [PubMed]
- Kheiri, A.; Moosawi Jorf, S.A.; Mallihipour, A.; Saremi, H.; Nikkhah, M. Application of chitosan and chitosan nanoparticles for the control of Fusarium head blight of wheat (Fusarium graminearum) in vitro and greenhouse. Int. J. Biol. Macromol. 2016, 93, 1261–1272. [Google Scholar] [CrossRef] [PubMed]
- El-Naggar, N.E.A.; Saber, W.I.; Zweil, A.M.; Bashir, S.I. An innovative green synthesis approach of chitosan nanoparticles and their inhibitory activity against phytopathogenic Botrytis cinerea on strawberry leaves. Sci. Rep. 2022, 12, 3515. [Google Scholar] [CrossRef] [PubMed]
- Zhang, Y.; Dai, J.; Ma, X.; Jia, C.; Han, J.; Song, C.; Liu, Y.; Wei, D.; Xu, H.; Quin, J.; et al. Nano-emulsification essential oil of Monarda didyma L. to improve its preservation effect on postharvest blueberry. Food Chem. 2023, 417, 135880. [Google Scholar] [CrossRef]
- Sun, X.; Narciso, J.; Wang, Z.; Ference, C.; Bai, J.; Zhou, K. Effects of chitosan-essential oil coatings on safety and quality of fresh blueberries. J. Food Sci. 2014, 79, M955–M960. [Google Scholar] [CrossRef]
- Black-Solis, J.; Ventura-Aguilar, R.I.; Correa-Pacheco, Z.; Corona-Rangel, M.L.; Bautista-Baños, S. Preharvest use of biodegradable polyester nets added with cinnamon essential oil and the effect on the storage life of tomatoes and the development of Alternaria alternata. Sci. Hortic. 2019, 245, 65–73. [Google Scholar] [CrossRef]

| Peak n° | RT | Compound | % Abundance | Area | CAS |
|---|---|---|---|---|---|
| 1 | 14.94 | Caffeine | 10.159 | 506,873 | 58-08-2 |
| 2 | 16.00 | n-Hexadecanoic acid | 14.344 | 715,646 | 57-10-3 |
| 3 | 17.64 | 17-Octadecynoic acid | 12.244 | 610,906 | 34450-18-5 |
| 4 | 22.40 | 1H-Indene, 2,3-dihydro-4,7-dimethyl- | 19.759 | 985,831 | 6682-71-9 |
| 5 | 22.96 | Benzimidazole, 2-methyl-1-(3-phenylpropylthio)methyl- | 10.540 | 10.540 | 615-15-6 |
| 6 | 23.19 | Norethindrone | 20.9440 | 20.944 | 68-22-4 |
| Peak n° | RT | Compound | Area | CAS | Formula |
|---|---|---|---|---|---|
| 8 | 9.6 | Delphinidin 3-O-galactoside | 96,352 | 197250-28-5 | C21H21O12 |
| 10 | 9.9 | Delphinidin 3-O-arabinoside | 115,798 | 28500-01-8 | C20H19O11 |
| 11 | 10.7 | Kaempferol 3-O-rhamnoside | 216,143 | 482-39-3 | C21H19O10 |
| 12 | 11.9 | Isorhamnetin 3-O-galactoside | 397,750 | 5041-82-7 | C22H22O12 |
| 13 | 13 | Quercetin 3-O-acetyl-rhamnoside | 675,166 | Not available | C23H22O12 |
| 14 | 14 | Theaflavin | 2,433,133 | 4670-05-7 | C29H24O12 |
| 15 | 15.0 | Andrographolide | 1,412,321 | 5508-58-7 | C20H30O5 |
| 20 | 15.4 | Kaempferol | 9,936,525 | 520-18-3 | C15H10O6 |
| 24 | 16.3 | Kaempferol 3-O-(6″-acetyl-galactoside) 7-O-rhamnoside | 658,288 | 124097-45-6 | C29H32O16 |
| 28 | 17.3 | Malvidin 3-O-(6″-p-coumaroyl-glucoside) | 9,548,757 | 158189-28-7 | C32H31O14 |
| 33 | 18.4 | Biochanin A | 1,985,709 | 491-80-5 | C16H12O5 |
| 37 | 19.5 | Ligstroside | 958,156 | 35897-92-8 | C25H32O12 |
| 42 | 20.7 | 3-Hydroxyphloretin 2′-O-xylosyl-glucoside | 1,290,713 | Not available | C26H32O15 |
| 48 | 22.6 | Resveratrol 3-O-glucoside | 1,275,343 | 38963-95-0 | C20H22O8 |
| 51 | 23.7 | p-HPEA-EDA | 8,929,194 | 151194-92-2 | C17H20O5 |
| 55 | 24.4 | Secoisolariciresinol-sesquilignan | 446,635 | Not available | C30H38O10 |
| 56 | 24.5 | Isorhamnetin 3-O-rutinoside | 801,069 | Not available | C22H22O11 |
| 57 | 24.6 | Luteolin 7-O-glucuronide | 462,237 | 29741-10-4 | C21H18O12 |
| 59 | 25.4 | 2-[4-(Diethylamino)-2-hydroxybenzoyl]benzoic acid | 8,324,925 | 5809-23-4 | C18H19NO4 |
| 60 | 25.5 | 2-S-Glutathionyl caftaric acid | 21,393,122 | Not available | C23H27N3O15S |
| 61 | 25.7 | Dehydroeburicoic acid | 48,266,948 | 6879-05-6 | C31H48O3 |
| 61 | 25.9 | Dihydromyricetin 3-O-rhamnoside | 4,582,788 | Not available | C21H22O12 |
| 64 | 26.4 | Cyclolariciresinol | 390,934 | 548-29-8 | C20H24O6 |
| 71 | 29.2 | Artemisinin | 500,292 | 63968-64-9 | C15H22O5 |
| Treatment | Grow Rate (mm/day) | Mycelial Growth on the Last Day | Inhibition of Mycelial Growth (%) | Inhibition of Spore Germination (%) |
|---|---|---|---|---|
| Control | 7.25 | 50 ± 0 d | 0 a | 0 |
| CP 1% | 7.19 | 48.14 ± 1.11 d | 3.72 bc | −7.98 |
| CP 5% | 6.55 | 44.31 ± 4.22 c | 11.38 c | 4.19 |
| CP 10% | 3.16 | 24.01 ± 3.42 b | 51.98 d | NSF |
| GCBO 1% | NG | 0 a | 100 f | NSF |
| GCBO 3% | NG | 0 a | 100 f | NSF |
| GCBO 6% | NG | 0 a | 100 f | NSF |
| NC 1% | 7.09 | 47.54 ± 1.20 d | 4.92 bc | −3.39 |
| NC 10% | NG | 0 a | 100 f | NSF |
| NC 20% | NG | 0 a | 100 f | NSF |
| Ch 1% | 7.37 | 49.43 ± 0.45 d | 1.14 ab | −3.39 |
| Ch 10% | NG | 0 a | 100 f | NSF |
| Ch 20% | NG | 0 a | 100 f | NSF |
| ChNp 1% | 7.18 | 48.08 ± 1.640 d | 3.84 b | −8.98 |
| ChNp 10% | NG | 0 a | 100 f | NSF |
| ChNp 20% | NG | 0 a | 100 f | NSF |
| Treatment | Grow Rate (mm/Day) | Mycelial Growth on the Last Day | Inhibition of Mycelial Growth (%) | Inhibition of Spore Germination (%) |
|---|---|---|---|---|
| Control | 1.26 | 50 ± 0 d | 0 a | 0 a |
| CP 1% | 1.28 | 50 ± 0 d | 0 a | 12.93 ef |
| CP 5% | 1.28 | 50 ± 0 d | 0 a | 17.86 ef |
| CP 10% | 1.28 | 50 ± 0 d | 0 a | 16.25 f |
| GCBO 1% | 0.66 | 28.31 ± 7.41 b | 43.38 de | NSF |
| GCBO 3% | 0.54 | 24.20 ± 2.01 b | 51.6 e | NSF |
| GCBO 6% | 0.83 | 34.25 ± 1.17 c | 31.5 d | NSF |
| NC 1% | 1.24 | 48.55 ± 1.19 d | 2.9 b | 4.72 bcd |
| NC 10% | 0.54 | 24.14 ± 6.03 b | 51.72 e | 1.92 b |
| NC 20% | NG | 0 a | 100 f | NSP |
| Ch 1% | 1.28 | 50 ± 0 d | 0 a | 8.21 cde |
| Ch 10% | 1.14 | 45.02 ± 0.69 d | 9.96 c | 3.32 def |
| Ch 20% | NG | 0 a | 100 f | 14.51 bc |
| ChNp 1% | 1.24 | 48.63 ± 1.28 d | 2.74 b | NSF |
| ChNp 10% | NG | 0 a | 100 f | NSF |
| ChNp 20% | NG | 0 a | 100 f | NSF |
| Botrytis sp. | Rhizopus sp. | |||
|---|---|---|---|---|
| Treatment | Mycelial Growth on the Last Day (mm) | Inhibition of Mycelial Growth (%) | Mycelial Growth on the Last Day (mm) | Inhibition of Mycelial Growth (%) |
| Control | 50 ± 0 | 0 a | 50 ± 0 b | 0 a |
| PET | 44.16 ± 16 | 11.68 b | 42.86 ± 3.68 b | 14.28 b |
| PPCP | 40.61 ± 2.08 | 18.78 b | 42.11 ± 8.09 b | 15.78 b |
| PPCP+NC | 40.60 ± 4.99 | 18.8 b | 0 a | 100 c |
| PP | 27.98 ± 2.62 | 44.04 c | 0 a | 100 c |
| PP+NC | 18.48 ± 5.87 | 63.04 d | 0 a | 100 c |
Disclaimer/Publisher’s Note: The statements, opinions and data contained in all publications are solely those of the individual author(s) and contributor(s) and not of MDPI and/or the editor(s). MDPI and/or the editor(s) disclaim responsibility for any injury to people or property resulting from any ideas, methods, instructions or products referred to in the content. |
© 2025 by the authors. Licensee MDPI, Basel, Switzerland. This article is an open access article distributed under the terms and conditions of the Creative Commons Attribution (CC BY) license (https://creativecommons.org/licenses/by/4.0/).
Share and Cite
Hernández-López, G.; Barrera-Necha, L.L. Coffee By-Products and Chitosan for Preventing Contamination for Botrytis sp. and Rhizopus sp. in Blueberry Commercialization. Resources 2025, 14, 48. https://doi.org/10.3390/resources14030048
Hernández-López G, Barrera-Necha LL. Coffee By-Products and Chitosan for Preventing Contamination for Botrytis sp. and Rhizopus sp. in Blueberry Commercialization. Resources. 2025; 14(3):48. https://doi.org/10.3390/resources14030048
Chicago/Turabian StyleHernández-López, Gonzalo, and Laura Leticia Barrera-Necha. 2025. "Coffee By-Products and Chitosan for Preventing Contamination for Botrytis sp. and Rhizopus sp. in Blueberry Commercialization" Resources 14, no. 3: 48. https://doi.org/10.3390/resources14030048
APA StyleHernández-López, G., & Barrera-Necha, L. L. (2025). Coffee By-Products and Chitosan for Preventing Contamination for Botrytis sp. and Rhizopus sp. in Blueberry Commercialization. Resources, 14(3), 48. https://doi.org/10.3390/resources14030048








